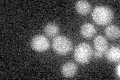
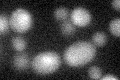

View description
Tetrameric histone acetyltransferase with similarity to Gcn5p, Hat1p, Elp3p, and Hpa3p; acetylates histones H3 and H4 in vitro and exhibits autoacetylation activity
Localization:
Intensity:
Fold change:
Significance:
-
C’ GFP library in SD
below threshold17.49 -
N' NOP1pr-GFP in SD

cytosol91.7162 -
N' TEF2pr-mCherry in SD

cell periphery,vacuole0 -
N' NATIVEpr-GFP in SD

below threshold19.8988 -
N' TEF2pr-VC and Cyto-VN in SD

#N/A0 -
C’ GFP library in SD+DTT
cytosol16.410.93No -
C’ GFP library in SD+H2O2

cytosol15.780.9No -
C’ GFP library in Starvation Media

cytosol17.240.98No -
C’ GFP library on the background of Pup2-DaMP

below threshold -
C’ GFP library on the background of CCT mutant

below threshold16.20030.925741No
